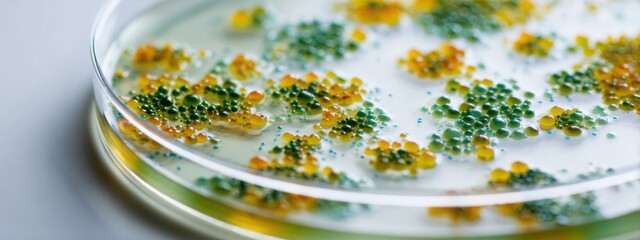
Bacterial growth in a petri dish shows diverse colors and shapes in a lab setting

- Home >
- Stock Photos >
- Diverse Scientists Collaborating with Mathematical Equations
Diverse Scientists Collaborating with Mathematical Equations Image

Diverse group of scientists working in a laboratory surrounded by complex mathematical equations. Reflects teamwork and collaboration in scientific research environments. Suitable for themes related to global science, interdisciplinary communication, and innovative research in the STEM fields. Potential use in educational materials or promotional content for scientific organizations.
downloads
Tags:
More
Credit Photo
If you would like to credit the Photo, here are some ways you can do so
Text Link
photo Link
<span class="text-link">
<span>
<a target="_blank" href=https://pikwizard.com/photo/diverse-scientists-collaborating-with-mathematical-equations/32fd45eece6fc1148dfde62c6fb48c23/>PikWizard</a>
</span>
</span>
<span class="image-link">
<span
style="margin: 0 0 20px 0; display: inline-block; vertical-align: middle; width: 100%;"
>
<a
target="_blank"
href="https://pikwizard.com/photo/diverse-scientists-collaborating-with-mathematical-equations/32fd45eece6fc1148dfde62c6fb48c23/"
style="text-decoration: none; font-size: 10px; margin: 0;"
>
<img src="https://pikwizard.com/pw/medium/32fd45eece6fc1148dfde62c6fb48c23.jpg" style="margin: 0; width: 100%;" alt="" />
<p style="font-size: 12px; margin: 0;">PikWizard</p>
</a>
</span>
</span>
Free (free of charge)
Free for personal and commercial use.
Author: Authentic Images